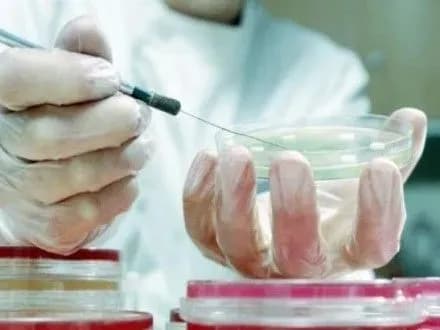
pershiy-letalniy-vipadok-vid-gripu-zareyestruvali-na-sumschini

"На 46 неделе 2016 года зарегистрирован летальный случай от гриппа в Сумской области, что подтверждается методом полимеразной цепной реакции", - говорится в бюллетене.
Всего в течение 14-20 ноября в Украине гриппом и ОРВИ заболело 170 552 человек, из них 68,1% дети до 17 лет. Показатель заболеваемости в Украине составляет 400,4 на 100 000 населения, что на 6,3% больше по сравнению с прошлой неделей.
В общем, как говорится, во всех регионах страны в указанный период показатели заболеваемости гриппом и ОРВИ не превышают эпидемические пороги и находятся в пределах от -0,9% в Львовской до -64,0% в Ивано-Франковской областях.
Самый высокий показатель заболеваемости зарегистрирован в Киевской области (780,8 на 100 тыс.), наименьший - в Тернопольской (213,8 на 100 тыс.).
Как сообщал УНН, во Львовской области на 43-й неделе зарегистрирована смерть ребенка в результате ОРВИ.